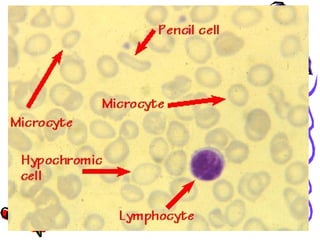

Thiếu máu thiếu sắt là một tình trạng phổ biến ở trẻ em, thường do dinh dưỡng không đủ sắt hoặc hấp thu kém. Triệu chứng bao gồm da xanh, mệt mỏi, và suy giảm phát triển, trong khi chẩn đoán dựa vào nồng độ ferritin và xét nghiệm máu. Điều trị bao gồm bổ sung sắt qua thực phẩm và thuốc, đồng thời duy trì chế độ dinh dưỡng hợp lý.